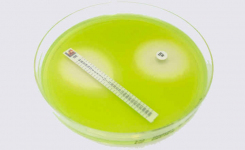
MIC Test Strip

Environmental Monitoring: Test air, surfaces, and personnel in manufacturing areas for microbial contamination with Liofilchem’s gamma irradiated, triple-enveloped settle plates (including 30mL volume/plate) and contact plates, which are individually packed in transparent blister packs.
Growth Promotion Testing: Our Quanti-CultiControl are lyophilized, quantitative microorganism preparations to be used for QC purposes. Processed as directed, these preparations provide a challenge of <100 CFU per 0.1 mL, a concentration useful for growth promotion testing of culture media to be employed in sterility testing. These microorganism preparations are derived from the American Type Culture Collection (ATCC®). The Quanti-CultiControl do not need any intermediate dilution steps, since each rehydrated suspension generates less than 100 UFC for 0.1 mL inoculum. Each suspension (1 mL) allows 10 inocula.
Biological Indicators: International Pharmacopoeiae recommend the use of bioindicators (BI) during the sterilization processes of drugs, medicines in vials, culture media, medical instruments and others. BIs are used for the validation, qualification, and monitoring of sterilization processes and are available as ampoule, self-contained, strip, suspension and coupon formats in several materials such as glass, aluminum, poliflex, steel, and PVC. We also produce custom-sized Biological Indicators on request.
Sterility Testing: We produce Fluids A, D, K, and Thioglycollate (FTM), used for ensuring the sterility of injectables, non-injectables, liquid products, oils and ointments, antibiotic powders, sterile pathway devices, and aerosols. These formulations are available in a wide variety of bottle volumes, caps (injectable, flip-off, etc.), or gamma-irradiated formats.
Water Testing: We produce ready-to-use 60mm diameter agar plates for water testing, including formulations such as R2A agar and many others.
Microbial Identification: Liofilchem produces galleries and individual biochemical tests for microbial identification.
Liofilchem also produces a wide range of dehydrated or ready to use culture media in agar plates, tubes, bottles and bags for the Bioburden Testing, Raw Material Testing and Antimicrobial Effectiveness Testing (AET).